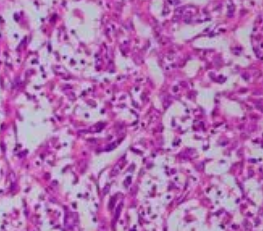
微信截图_20220427152424.png

DyLight 594-UEA I;DyLight 594标记的荆豆凝集素(UEA-I),DyLight 594 labeled Ulex Europaeus Agglutinin I (UEA I)
武汉pg电子娱乐游戏app
生物制品体**出售一类型的凝集素;同時给出各类荧光标注遮盖偶联的凝集素。给出罗丹明、CY3、CY5、FITC、生物制品体素Biotin、琼脂糖Agarose、DyLight 488、DyLight 594、DyLight 649、Texas Red标注各类凝集素。凝集素(Lectin)指得一类从一些绿植,无脊椎骨猎物和中等职业猎物中分离纯化的糖核淀粉酶或相运用糖的核淀粉酶,因为它的能凝集红血球(含血型物资),故名凝集素。较常用的为绿植凝集素(Phytoagglutin,PNA),普通其所被导入的绿植被命名,如刀豆素A(Conconvalina,ConA)、麦胚素(Wheat germ agglutinin,WGA)、花生米凝集素(Peanut agglutinin,PNA)和玉米凝集素(Soybean agglutinin,SBA)等,凝集素是两者的总称。凝集素应该做为一类探头来研发内部膜上不同的糖基。别的的方面,凝集素具备多价相运用意识,能与FITC荧光素、动物素、酶、固体金和铁核淀粉酶等示踪物相运用,所以在光镜与/或电镜横向表明其相运用脏器。普通所采用荧光素、辣根过腐蚀物酶、铁核淀粉酶、固体金、Cyanine或动物素等对其通过标志。 如今至今荧光素异硫氰酸荧光素(fluorescein isothiocyanate,FITC)、辣根过脱色物酶和海洋生物体素标示凝集素的组织机构电学脱色。近两天,pg电子娱乐游戏app
海洋生物体企业投放市场了Cyanine纺织有机有机染料标示的凝集素楼盘新品Cyanine Dye Conjugated Lectin。与传统的的荧光纺织有机有机染料基团不同之处,Cyanine纺织有机有机染料兼具更强的荧光,且荧光不可以猝灭。此类Cyanine标示凝集素软件的面世,为宽广的凝集素顾客提拱了更大区间的选区间。Cy3共轭物促用带异罗丹明(TRITC)吸附器的荧光显微镜观测确定观测分析。但Cy5共轭物通畅用装备有远红外光谱图成相的共把握显微镜观测来确定观测分析。这个Cyanine标上的凝集素目的在于用以监定上皮上皮细胞和组织安排切成片上的糖蛋清传达。因此產品可多用以天然免疫荧光和普鲁士蓝染色上皮上皮细胞进行实验中。荆豆凝集素兼具抗H血型特喜欢的人。凝集赋有两类款式: UEA I对 L-岩藻糖兼具亲和,UEA II对N,N′-二乙酰基壳二糖兼具亲和。刚展开表示UEA I摩尔量为170,000道尔顿。 从前的通讯稿得出结论,UEA I会在碱式盐和酸碱度pH下行成聚全体,恰当的摩尔量是68,000道尔顿。

pg电子娱乐游戏app
微信公众号
官方微信